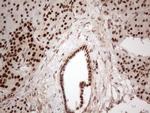
IRS1 Antibody in Immunohistochemistry (Paraffin) (IHC (P))

Search
OriGene
IRS1 Monoclonal Antibody (OTI3G10), TrueMAB™
{{$productOrderCtrl.translations['antibody.pdp.commerceCard.promotion.promotions']}}
{{$productOrderCtrl.translations['antibody.pdp.commerceCard.promotion.viewpromo']}}
{{$productOrderCtrl.translations['antibody.pdp.commerceCard.promotion.promocode']}}: {{promo.promoCode}} {{promo.promoTitle}} {{promo.promoDescription}}. {{$productOrderCtrl.translations['antibody.pdp.commerceCard.promotion.learnmore']}}
产品信息
TA808553
种属反应
宿主/亚型
分类
类型
克隆号
抗原
偶联物
形式
浓度
纯化类型
保存液
内含物
保存条件
运输条件
靶标信息
IRS-1, a major substrate of the insulin receptor, is phosphorylated in response to stimulation of cells by insulin, insulin-like growth factor 1 (IGF-1) and interleukin 4 (IL-4). IRS-1 is phosphorylated on serine, threonine and tyrosine residues in a variety of tissues. An insulin-sensitive serine/threonine kinase casein kinase II mediates a portion of the insulin-stimulated serine/threonine phosphorylation of overexpressed IRS-1 in vivo. Thr 502 is identified as the major casein kinase II-catalyzed phosphorylation site in rat IRS-1, and Ser 99 is an additional phosphorylation site catalyzed by casein kinase II. Thus, casein kinase II-catalyzed phosphorylation of IRS-1 may be a component of the intracellular insulin signaling cascade. IRS-1 contains three putative binding sites for 14-3-3 (Ser 270, Ser 374 and Ser 641) and the motif around Ser 270 is located in the phosphortyrosine binding domain of IRS-1, which is responsible for the interaction with the insulin receptor.
仅用于科研。不用于诊断过程。未经明确授权不得转售。
篇参考文献 (0)
生物信息学
蛋白别名: Insulin receptor substrate 1; IRS-1
基因别名: HIRS-1; IRS1
UniProt ID: (Human) P35568
Entrez Gene ID: (Human) 3667